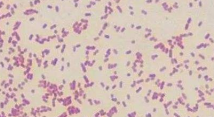
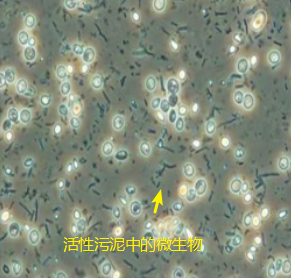

微生物处理工业废水
近年来,有关微生物处理工业废水的研究方向越来越受到重视。目前关于废水处理中环境微生物的研究主要涉及不同废水处理时活性污泥中微生物群落结构及种群多样性变化、废水中各类有机、无机污染物对污泥中微生物毒性影响、微生物群落结构在不同处理工艺、不同反应器、不同运行参数下的变化等。从活性污泥中取样,用特定引物对样品分离出的DNA进行扩增,构建出样品的16S rDNA克隆文库,比对酶切后产物得到的RFLP图谱,根据此图谱的结果对其微生物群落结构进行分析,这类研究方法为在水处理过程中日趋成熟 ,其中,荧光原位杂交技术(Fluorescence in situ hybridization, FISH),变性梯度凝胶电泳技术(DGGE),扩增rDNA限制酶切分析(Amplified ribosomal DNA rest rict ion analysis, ARDRA)技术,能够直接检测样品中菌群的结构和丰度。

废水处理流程
一、废水中常见的微生物
工业废水大多为有机废水,里面的活性污泥包含各种微生物菌,成分复杂,细菌占据主体,细胞产生胞外多聚物(Extracellular polymeric substances, EPS)与微生物形成的菌胶团以及丝状菌构成了活性污泥的骨架,促使活性污泥以生物絮体的形式存在,并通过重力沉降使活性污泥从处理后的液体中分离出来。根据各种资料显示,汇总,活性污泥菌中占优势的主要有几下几种:产气杆菌属(Aerobacter)、产碱杆菌属(Alcaligenes)、芽孢杆菌属(Bacillus)、黄杆菌属(Flavobacterium)、假单胞菌属(Pseudomonas)、诺卡氏菌(Nocardia)、动胶菌属(Zoogloea)、变型菌类(Proteus)、大肠杆菌(E. coli)等。另外,在活性污泥中存在大量有丝状菌,如球衣菌属(Sphaerotilus)、发硫细菌(Thiothrix)、诺卡氏菌(Nocardia)、各种霉菌等丝状微生物,这些细菌可以交叉穿织于菌胶团之间或附着于絮体表面,少量的可游离于污泥之间,这类细菌对有机物同样很强的氧化降解能力,但在少数情况下可能超过菌胶团细菌,使污泥絮体沉降性变差,产生严重的污泥膨胀,造成出水水质下降。
 芽孢杆菌
芽孢杆菌
气单胞菌
气单胞菌
二、生物分析技术
(1)荧光原位杂交技术
根据碱基互补配对原则,可以利用核酸分子杂交技术直接探测溶液中细胞组织内或固定在膜上的同源核酸序列核酸分子杂交的高度特异性以及检测方法的高度灵敏性,使核酸杂交技术广泛应用于环境微生物的检测,并可以对微生物的存在分布丰度和适应性等进行定性和定量分析,可得出相应微生物在活性污泥总生物量中所占比例 。

荧光原位杂交技术
(2)DGGE(变性梯度凝胶电泳)
DGGE技术是用于检测DNA的一种电泳技术,DGGE技术用于微生物多样性研究,可以从活性污泥中获得微生物总DNA,然后运用16Sr DNA通用引物进行PCR扩增,可以得到与碱基长度相同的细菌16Sr DNA。采用DGGE技术能够分离PCR产物,根据电泳条带的多寡和条带的位置,可以初步辨别样品中微生物种类的多少,进而分析活性污泥中微生物的多样性。PCR-DEEG技术目前在分析微生物多样性、监测微生物群落动态性、发现新的微生物物种等方面起到了重要的作用。

(3) 克隆文库
针对微生物的16S rRNA或功能基因进行选择性扩增进行计数,用核酸测序技术研究微生物生态和进化,将分子生物学技术应用于微生物生态学的研究,开辟了认识环境中微生物的新方法。近年来,污水生物处理技术研究的一个重要特征,分子生物学技术在污水处理系统选择性的培养,最终将带有正确长度插入片段的克隆筛选出来,再测定克隆产物的基因序列,通过与Gene Bank数据库中已有数据的对比,即可鉴定目标微生物的系统发育地位,许多序列可以鉴定到种的水平。
活性污泥中微生物群落分布广泛,多样性指数很高,对工业废水中的有机物降解发挥了不可替代的作用。水处理过程中,水解酸化阶段一般可增加活性污泥的微生物种类,能够使废水的处理向好的方向变化,因此过外界条件的调节可以改善微生物种群结构,从而使废水能被更高效地处理。

全国服务热线
全国服务热线
 电话:136-8234-1316
电话:136-8234-1316 微信:13538246963
微信:13538246963 邮箱:yiqing@wlw13.cn
邮箱:yiqing@wlw13.cn 手机:13538246963
手机:13538246963 地址:广东省广州市天河区华南农业大学金慧路88
地址:广东省广州市天河区华南农业大学金慧路88






